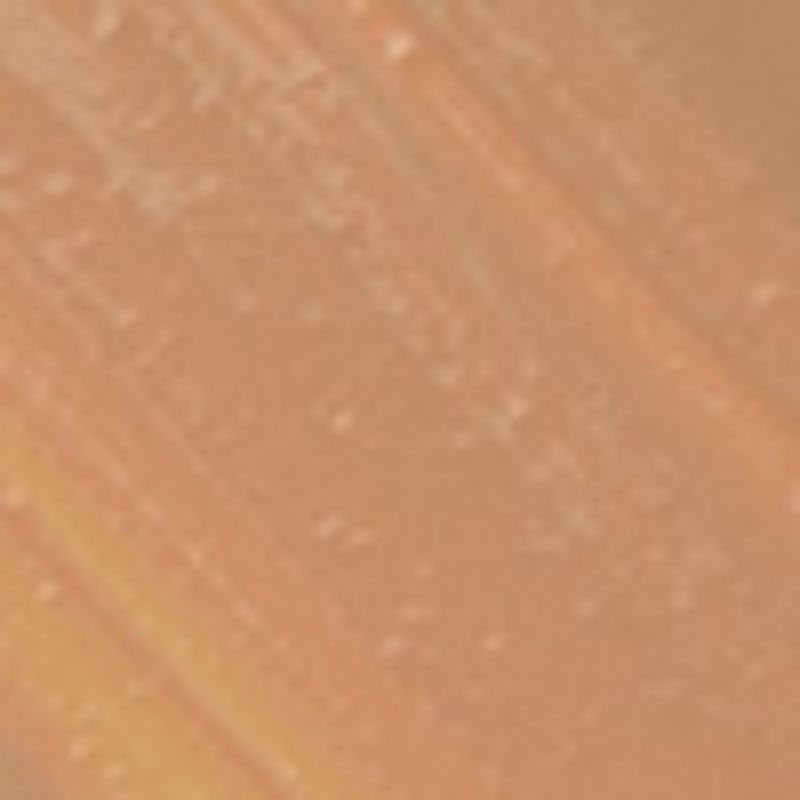
product-thumbnail

Milani Conceal + Perfect Long Wear Concealer Warm Beige(5ml)
4.4/5
1736 ratings
&
76 reviews
Regular price ₹1795. Discounted price ₹1436. 20% Off.
inclusive of all taxes
Nykaa maintains pricing batches within its inventory, which can lead to changes in final MRP.
Delivery Options
100% Genuine Products
100% Authentic, directly purchased from Milani.
Easy Return Policy
Returns/replacements are accepted for unused products only in case of defects, damages during delivery, missing, or wrong products delivered. Return requests can be raised on the 'My Order' section within 15 days of delivery.
Sold by :Nykaa E retail limited
Product Details
Ratings & reviews
How may we help you